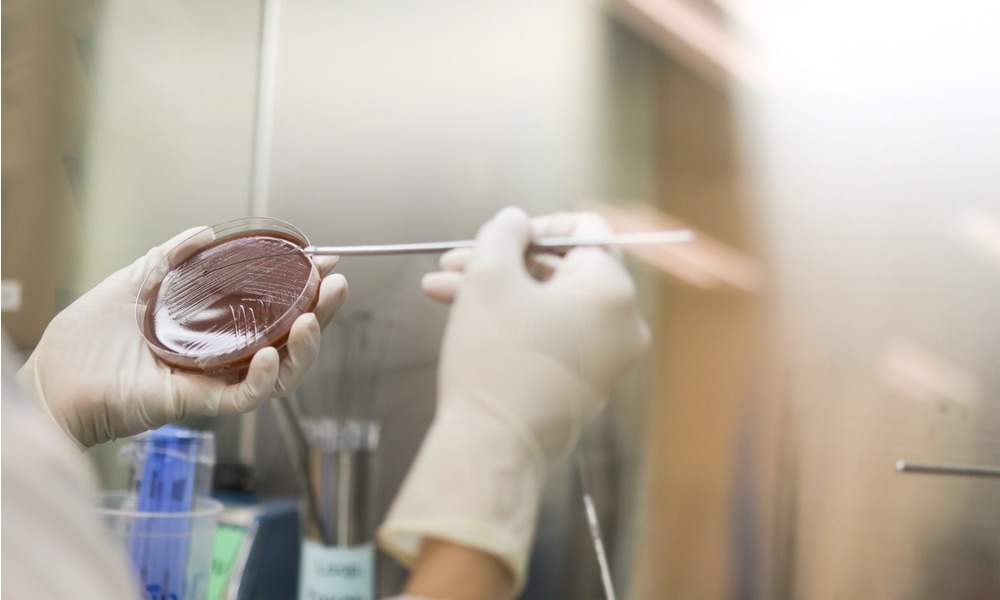
MyCollages - 2025-11-07T111525.066.jpg MyCollages - 2025-11-07T111525.066.jpg

Термин ИППП, обозначающий инфекции, передающиеся половым путем, включает в себя множество заболеваний, спровоцированных различными патогенными микроорганизмами — от бактерий и вирусов до грибков и паразитов.
В наши дни термин ИППП охватывает не только традиционные венерические заболевания, но и ряд других инфекций, которые сравнительно недавно были включены в эту категорию после того, как ученые доказали их способность передаваться при сексуальных контактах.
Какими они бывают
Инфекции, передающиеся через половые контакты, можно классифицировать исходя из типа возбудителя.Среди бактериальных инфекций можно назвать сифилис, который вызывает бледная трепонема, гонорею, провоцируемую гонококком, хламидиоз, обусловленный хламидией, а также патологии, связанные с микоплазмами и уреаплазмами. Подобные микроорганизмы становятся причиной воспалений в органах мочеполовой системы, а заражение чаще всего происходит во время интимных контактов.
К вирусным инфекциям относятся ВИЧ, который может привести к развитию СПИДа, ВПЧ, вызывающий образование папиллом и кондилом, которые могут стать фактором риска развития онкологического заболевания половых органов. Кроме того, в эту категорию входят гепатиты B и C: негативно влияющие на работу печени и способные передаваться не только половым, но и парентеральным способом.
В числе протозойных инфекций (вызванных простейшими) можно выделить трихомониаз: это заболевание возникает при заражении простейшим одноклеточным организмом Trichomonas vaginalis.
Есть также заболевания, вызванные паразитическими насекомыми: сюда причисляют чесотку, возникающую из-за Sarcoptes scabiei (микроскопического клеща) и фтириаз, провокатором которого являются лобковые вши. Такие паразиты способны заражать через тесное соприкосновение, одежду или белье и через прочие предметы.
Среди грибковых инфекций стоит упомянуть кандидоз, более известный как молочница: его возбудитель — дрожжеподобный грибок Candida. Хотя кандидоз не всегда рассматривается как инфекция, передающаяся половым путем (поскольку часто возникает вследствие дисбаланса микрофлоры), передача грибка при интимных контактах все же возможна. Также есть вероятность передачи через предметы быта, например, общие полотенца.

Пути их распространения
Заболевания, которые передаются половым путем (ЗППП), чаще всего распространяются посредством интимных контактов — вагинального, орального или анального без применения барьерных методов контрацепции. В ходе подобных контактов происходит взаимодействие слизистых оболочек и обмен различными биологическими жидкостями, включая сперму, влагалищный секрет, слюну и кровь, что способствует передаче патогенных микроорганизмов от зараженного человека к здоровому. Именно непосредственное соприкосновение слизистых оболочек выступает ключевым фактором в распространении венерических заболеваний. Медицинские данные свидетельствуют о том, что большинство ИППП передается исключительно при половых контактах, а риск инфицирования в бытовых условиях минимален.Но все же существуют альтернативные пути распространения данных инфекций. Один из таких путей — парентеральный, подразумевающий попадание инфекции в кровь: такое заражение возможно в процессе переливания крови, пользования общим нестерильным шприцем, применения нестерильных медицинских инструментов повторно во время проведения косметических процедур, например, татуажа, пирсинга или маникюра. Таким способом могут передаваться ВИЧ, гепатиты B и C, сифилис и ряд других заболеваний.
Еще один путь передачи — вертикальный, то есть от матери к ребенку. Женщина, зараженная инфекцией, способна передать некоторые заболевания своему ребенку в период вынашивания плода или во время родов при прохождении ребенка по родовым каналам или в процессе грудного вскармливания. К числу таких инфекций относятся сифилис, ВИЧ, гонорея, гепатиты В и С, трихомониаз, герпес, хламидиоз и другие.
Также существует риск самоинокуляции: когда человек является носителем возбудителя, он может непреднамеренно распространить его на другие части тела, например, с половых органов на глаза, нос или рот посредством грязных рук. Известны случаи, когда в результате такого заноса инфекции возникал хламидийный конъюнктивит или орофарингеальный хламидиоз.
Но что случится, если болезнетворные микроорганизмы окажутся за пределами человеческого организма — скажем, на каких-либо предметах обихода? Сохранят ли они свою способность вызывать заболевание при обычном контакте? Как долго возбудители ИППП могут сохранять жизнеспособность в окружающей среде.
Почему эти инфекции почти не передаются бытовым путем
Вероятность передачи венерических заболеваний крайне низка, и этому есть научное объяснение. Дело в том, что патогенные микроорганизмы, вызывающие подобные заболевания, эволюционно не приспособлены к выживанию в условиях, отличных от внутренней среды человеческого организма. Они крайне восприимчивы к изменениям окружающей среды — температуры, уровня влажности и другим внешним факторам.Если такие микроорганизмы попадают на предметы обихода (например, на стол), их жизнедеятельность быстро прекращается. Микроорганизмы, поражающие половые органы, не способны долго существовать в местах с пониженной температурой и низким уровнем влажности, в том числе на кромке унитаза или на полу. Продолжительность жизни патогенов вне человеческого тела варьируется в зависимости от их разновидности.
Бактерии, провоцирующие венерические заболевания (бледная спирохета, хламидии и другие), за пределами слизистых оболочек человека живут недолго. Отсутствие влаги, солнечный свет, мыло и комнатная температура быстро приводят к их гибели. Гонококк — возбудитель гонореи — утрачивает жизнеспособность за считаные минуты, в редких случаях — моментально. Ответственная за сифилис бледная трепонема тоже крайне уязвима и может недолго существовать только при низкой температуре и высокой влажности. Риск заражения этими заболеваниями через предметы крайне мал.
Вирусы иногда проявляют большую устойчивость вне человеческого тела по сравнению с бактериями. Так, безоболочечные вирусы, включая ВПЧ, способны сохранять жизнеспособность на предметах дольше, чем оболочечные (например, ВИЧ или вирус герпеса). Однако и они со временем теряют способность инфицировать. Вирус иммунодефицита вне тела человека теряет свои свойства в течение нескольких минут или, в крайнем случае, нескольких часов: он чувствителен к высыханию, перепадам температуры и дезинфицирующим средствам. Вирусы гепатита B и C более устойчивы: первый может сохраняться в засохших пятнах крови до нескольких недель, а второй — до нескольких дней. Однако даже в таких случаях для инфицирования необходимо соприкосновение с кровью или слизистой оболочкой, а обычное нахождение рядом с зараженным не позволяет вирусам проникнуть в организм.
Протозойные инфекции и паразитические насекомые представляют собой особую группу. Например, трихомонада может некоторое время существовать, но только при условии повышенной влажности (к примеру, на слизистой оболочке влагалища), а вот вне организма человека (к примеру, на бортике бассейна или полотенце) она быстро погибает. Чесоточный клещ и лобковые вши проявляют большую устойчивость независимо от тела человека: они могут перемещаться на бельё, постельные принадлежности или полотенца и ждать нового хозяина. Таким образом некоторые паразиты способны заражать не только при тесном интимном взаимодействии, но и бытовым путем — через общие вещи.

Что такое входные ворота и почему так важно беречь слизистые оболочки и кожу от повреждений
Допустим, что на каком-либо предмете оказались патогенные микроорганизмы, вызывающие инфекции, передающиеся половым путем (ИППП). Возможно ли в таком случае инфицирование другого человека? Ответ на этот вопрос во многом зависит от способности микроорганизма проникнуть внутрь организма. Кожный покров человека — это мощный барьер, который в большинстве случаев успешно препятствует проникновению болезнетворных агентов. При попадании на здоровую кожу частиц, содержащих патогены, эти частицы не смогут преодолеть ее верхний слой.Однако существуют входные ворота, через которые инфекция может попасть внутрь. К ним относятся слизистые оболочки (например, во рту, половых органах и глазах) и поврежденная кожа. К примеру, если на коже имеется ранка или царапина и на это место попадет кровь, содержащая вирус, риск инфицирования значительно возрастает.
В обычных условиях кожный покров надежно защищает нас от патогенных микроорганизмов, однако на коже большинства людей присутствуют микротравмы — едва заметные царапинки и потертости. Теоретически при наличии повреждений возможно инфицирование, но для бытового заражения необходимо стечение нескольких обстоятельств:
- на поверхности должно быть значительное количество жидкостей, которые выделяют зараженные люди (крови, спермы, вагинальных выделений, слюны или мочи);
- концентрация патогенных микроорганизмов в этих жидкостях должна быть достаточно высокой, поскольку небольшое количество бактерий или вирусных частиц обычно не приводит к развитию заболевания;
- возбудители инфекций должны сохранить свою жизнеспособность — жидкие остатки, в которых они содержатся, не должны высохнуть или разрушиться, так как со временем вероятность выживания микробов снижается.
Презерватив не поможет: какие 5 ИППП и ЗППП могут передаваться даже при барьерной защите
Кстати, многие биологические выделения не представляют угрозы. В частности, пот и слезы не обладают необходимым количеством возбудителей ИППП для заражения, поэтому через контакт с потом или поверхностный поцелуй с ВИЧ-пациентом заразиться практически невозможно. Ведь несмотря на то, что в слюне может содержаться определенная доля инфекции, вероятность заражения через поцелуй возможна лишь в особых случаях — например, при глубоком поцелуе, когда во рту есть ранки или повреждения, или при более тесном контакте, таком как оральный секс.
Также стоит отметить, что воздушно-капельным путем (при чихании или кашле) ни одна из ИППП не передается, поскольку эти патогены быстро погибают или теряют инфекционную активность.
Бытовое заражение требует стечения маловероятных условий: выделения должны быть свежими и содержать высокую концентрацию возбудителей, а также практически немедленно попасть на уязвимые участки тела другого человека. В реальности такие ситуации возникают крайне редко, поэтому риск заболеть ИППП в быту почти равен нулю.








